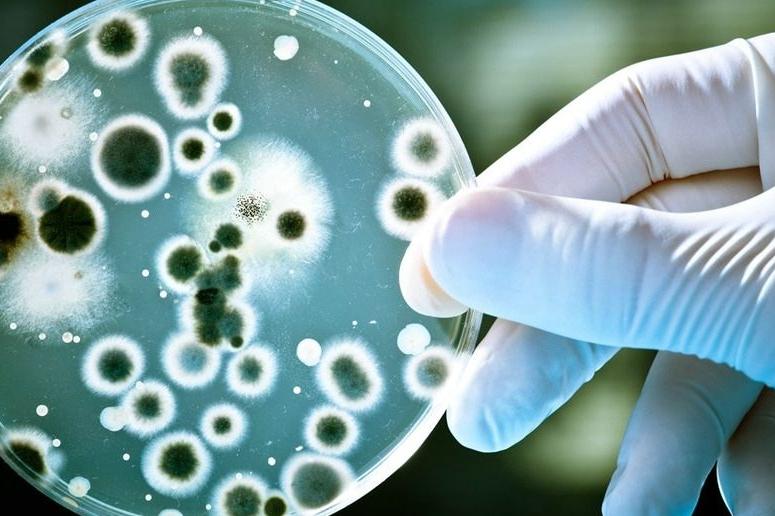
孢子吸入肺部会怎么样,吸入孢子会怎么样

导语:芽孢杆菌病是一种名为芽生菌的真菌造成的感染。菌类在环境中生长,尤其是在潮湿的土壤中,并分解木材和树叶等物质。细菌主要分布于美国和加拿大的俄亥俄、密西西比谷地以及五大湖附近。人吸入空气中的微小真菌孢子就会得芽生菌病。尽管大部分吸入孢子的人都不会生病,但也有一些人会出现发烧、咳嗽等症状,如果不加以治疗,感染有时会加重。

一、芽孢杆菌病
1、芽孢杆菌病是一种罕见的真菌感染
芽孢杆菌病是一种罕见的真菌感染,通常为芽孢真菌,也称芽孢真菌。这种菌类可在湿润的土壤中找到,尤其是在树木茂盛的地区和水路上。在安大略省、马尼托巴省以及美国中南部、东南部和中西部地区,芽孢菌病的发病率最高。芽生菌病在明尼苏达州的东北部地区最为普遍,但也可能在全州发生。除对人类病例进行监测外,明尼苏达州卫生部和动物卫生委员会也对动物芽生菌疾病病例进行了追踪。这样我们就可以更精确地描绘出发现这种疾病的州的范围。一年中,受感染的动物比人多,而且动物接触真菌的部位通常更容易识别。

2、芽孢杆菌
Blastomyces dermatitidis(芽孢杆菌)可能有两种,Blastomyces dermatitidis和Blastomyces gilchristii。芽孢杆菌主要生活在美国和加拿大地区。环绕着俄亥俄和密西西比河流域、五大湖和圣劳伦斯河。众所周知,所有芽孢杆菌都可以在不利的环境条件下形成休眠孢子。这些内生孢子可能会长期存活。内生孢子对热,化学物质和日光具有抵抗力,并且广泛分布在自然界中,主要分布在土壤中,并从土壤中侵入尘埃颗粒。
非洲和印度也报道了一些芽生真菌病的病例。急性肺芽生菌病可进展为急性呼吸窘迫综合征(ARDS)。有症状的病例中大约有25%至40%可发展为肺外感染,其典型症状包括皮肤、骨关节、泌尿生殖系统或中枢神经系统疾病。原发于皮肤的芽生菌病很少见,但是可以通过伤口接种引起。

3、动物也可能会被感染
除了人类,动物,比如狗,老鼠和猫也可能会被感染。这种疾病很少在人与人之间或动物与人之间传播。通过皮肤感染疾病的情况可能会很少发生。你可能接触潮湿的土壤,最常见的是接触腐烂的木材和树叶而导致该病。真菌通过肺部进入人体,从肺部开始感染。然后真菌可以扩散到身体的其他部位。这种疾病可能会影响皮肤、骨骼和关节等部位。
虽然几乎每个人都可能感染这种真菌,但芽生真菌病的最高风险是免疫抑制个体和那些生活在或访问真菌孢子丰富地区的人。由于真菌喜欢在潮湿的森林地区生长,猎人、林业工人、露营者和农民是感染芽生真菌病的高危人群。芽孢杆菌病不能从人传染给人或从动物传染给人。
二、芽孢杆菌的分类
1、蜡状芽孢杆菌
蜡状芽孢杆菌分为革兰氏阳性、好氧或兼性厌氧、孢子形成、运动、致病性和机会性细菌,能够在氧气存在下产生抗性内孢子。蜡状芽孢杆菌广泛分布在环境中,即土壤中,在不利条件下孢子持续存在。蜡状芽孢杆菌可在较宽的温度范围内生长(8-55°C),但不适于耐低pH值(最低5-6)或含水量(最低水活度0.95)。
这种革兰氏阳性菌在全世界所有温带地区的土壤、水和食物中都很常见。本品为兼性厌氧菌,能在鞭毛周围活动。该菌是食物传播疾病的主因之一,有可能引起呕吐综合征或中毒感染综合征。蜡状芽孢杆菌它也可引起多种非胃肠疾病,如心内膜炎、细菌性血症、眼内炎、慢性皮肤感染等。因为内孢子抗性强,蒸煮不能消除,冷冻也不能消除,但是冷冻并不能阻止食物的生长,所以如果想长期保存食物,最好在6℃以下。

2、枯草芽孢杆菌
产于土壤中的革兰氏阳性菌和过氧化氢酶阳性细菌。它是棒状的,圆形,长2-3微米,宽1微米。这种细菌几乎完全是有氧的,但能在缺氧的环境中存活。它被认为对人类是安全的,但也有个别的中毒案例,因为食用了受这种物种污染的食物。在这些病例中,症状与中毒症状相似。蜡状芽孢杆菌。
它是研究最多的细菌种类之一,研究人员认为它是革兰氏阳性的。大肠杆菌。它也被认为是实验室研究的模型生物,特别是在基因操纵研究中。枯草芽孢杆菌产生杆菌素,一种杀菌抗生素,能有效地治疗革兰氏阳性细菌,如金黄色葡萄球菌。它还生产具有抗真菌活性的生物活性化合物和用于生产洗涤剂的物质。

3、谁更容易患上芽生菌病?
任何人都可能患上芽生菌病,如果他们曾经在芽生菌生活的环境中生活中。在这些地区从事户外活动的人(如林业工作、打猎和露营)患芽生菌病的风险可能更高。免疫系统较弱的人比健康的人更容易患上严重的芽生菌病。
在细胞免疫水平较低的人身上,皮炎芽生菌似乎比正常人更不易引起疾病。肺部自然会保护被吸入的孢子,这也是我们观察到的原因。当免疫力低下的患者中出现芽生菌病时,其侵袭性比免疫力低下患者强。有资料表明,30%的病人死于细菌感染,这是常见的传播疾病和中枢神经系统损害。对艾滋病患者来说,芽生菌病是一种严重的疾病,其传播范围很广,通常包括中枢神经系统。

结语:芽孢杆菌病在美国中西部、东南部和中南部俄亥俄和密西西比河沿岸流行。芽生菌病是由芽生菌引起的一种罕见的传染病。细菌在霉菌孢子中生长并被吸入。对人而言,真菌会转变为酵母菌,然后侵入肺。细菌感染通过血液在全身传播,通常会损害免疫系统。